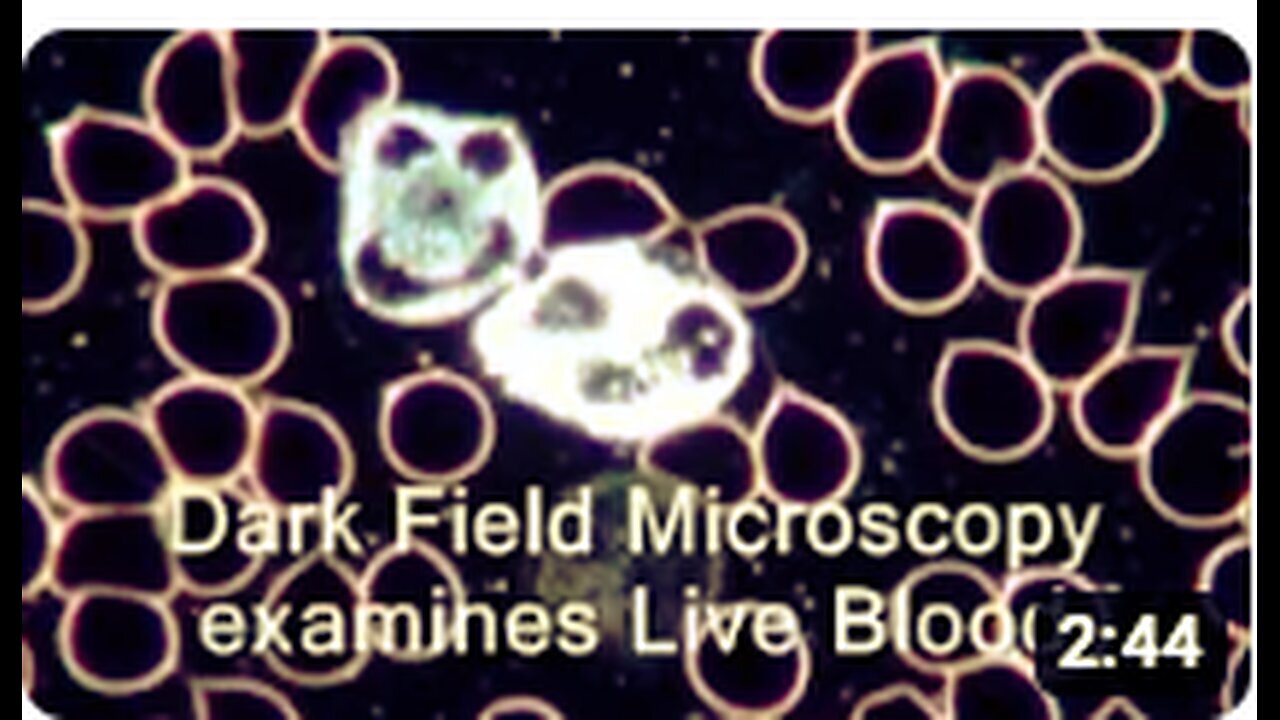

Premium Only Content
This video is only available to Rumble Premium subscribers. Subscribe to
enjoy exclusive content and ad-free viewing.
"Exploring Live Blood Analysis and Dark Field Microscopy - Part 2"
4 months ago
8
News
live blood analysis
dark field microscopy
health diagnosis
microscopic examination
cellular health
blood cell analysis
scientific explanations
medical technology
hematology
cellular biology
Live Blood Analysis Dark Field Microscopy explained 2
Loading comments...
-
56:52
Worldnews17
3 months ago"Zionist-Funded Tommy Robinson Stirs British Racial Conflict: An Exposé"
2.02K5 -
LIVE
Tundra Tactical
1 hour agoThe Great Tundra Nation Gaming Stream!!! Featuring ThePiggNation LAST DAY!!!!
57 watching -
1:50:18
The Quartering
2 hours agoWhat The Heck Is Even Happening?
83.8K12 -
DVR
iCkEdMeL
1 hour ago $2.09 earnedICE SHOOTS Popular TikToker ‘Richard’ During Raid in South L.A.?! 😳 What Really Happened LIVE
5.31K3 -
16:57
Clownfish TV
9 hours agoLord of the Rings is RACIST Again According to UK College Course... | Clownfish TV
89010 -
LIVE
The Nunn Report - w/ Dan Nunn
1 hour ago[Ep 774] Trump’s Ballroom Blitz | 9th Circuit OK’s Guard in Portland | Guest: Sam Anthony
111 watching -
1:05:27
DeVory Darkins
3 hours ago $31.77 earnedTrump scores HISTORIC IMMIGRATION WIN as Democrats STUNNED by ballroom renovations
107K49 -
43:40
The Rubin Report
2 hours agoDark Future Predictions & Exposing the Truth About Australia’s Past | Tony Abbott
23.3K11 -
1:57:45
The Charlie Kirk Show
4 hours agoThis is What Democracy Looks Like + Oxford Union Election Fraud? | Dr. Orr, Ogoloma, Harmon | 10.21
75.5K25 -
26:07
Lady Decade
11 hours agoGaming Feminists Just Discovered Islam - & It’s Not Going Well
26.6K7